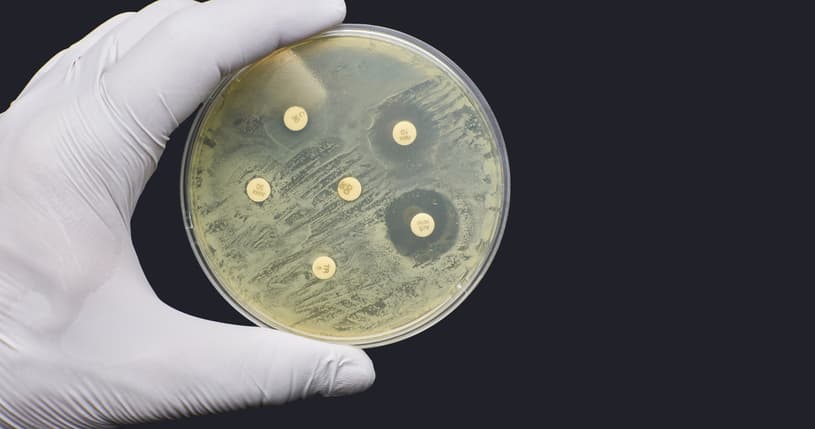
Antimicrobial resistance

23.10.2025
Antibiotics play a crucial role in the treatment of many serious diseases, including cancer. Although antibiotics do not cure cancer, they are essential for patients to receive and tolerate primary cancer treatment.
During chemotherapy or immunotherapy, the immune system becomes weakened. This makes cancer patients highly vulnerable to infections — meaning that even a simple pneumonia can become life-threatening. For this reason, patients often receive antibiotics for extended periods during treatment to prevent and fight dangerous infections. But that battle is becoming increasingly difficult, as bacteria are growing more resistant to our antibiotics.
Antibiotics don’t cure cancer – but they’re indispensable for cancer patients.
We are facing one of the greatest global threats to human health: Antibiotic resistance. According to a new report from the World Health Organization (WHO), one in six bacterial infections worldwide is now resistant to antibiotic treatment. In addition to affecting poorer regions of the world, this will especially impact vulnerable patients — including cancer patients whose immune systems are weakened by treatment.
If we are to continue using the many innovative cancer therapies available now and in the future, it is crucial that we secure access to effective antibiotics. Combating antibiotic resistance must therefore be a top priority.
Without effective antibiotics, curing cancer becomes far more difficult — if not impossible.
Pharmadanmark is taking the lead in putting antibiotic resistance on the agenda. Together with the Novo Nordisk Foundation and Pfizer Denmark, we have established the AMR Alliance, which works to address and solve the challenges related to antibiotic resistance.
The Alliance has advocated for the new national action plan against antimicrobial resistance, which focuses on strengthening infection prevention, reducing antibiotic use, and promoting the development of new antimicrobial medicines.
In November, the Alliance will co-host a two-day EU conference on AMR, where you can learn more about how antibiotic resistance affects patients — and what European hospitals are doing to fight resistance. The conference focuses on concrete solutions and actions as both Danish and international experts and policymakers take the stage.
Among the speakers are representatives from the Union for International Cancer Control (UICC), who will share their personal experiences of how resistance has affected their cancer journey — and why access to effective antibiotics is so vital.

Conference on AMR
At the AMR Conference on 19 and 20 November in Aarhus and Copenhagen, we focus on solutions to combat antibiotic resistance.